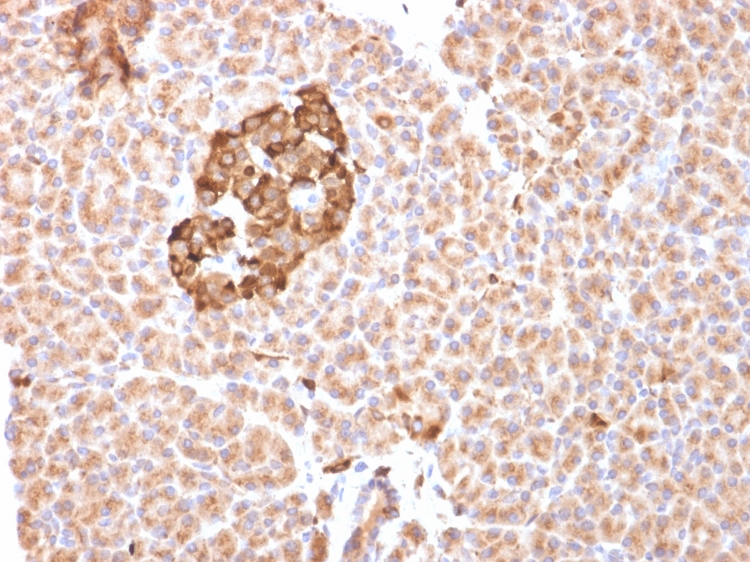

Formalin-fixed, paraffin-embedded human pancreas stained with Ferritin, Heavy Chain Mouse Monoclonal Antibody (FTH/2081). Confirmation of Purity and Integrity of Antibody.
Formalin-fixed, paraffin-embedded human pancreas stained with Ferritin, Heavy Chain Mouse Monoclonal Antibody (FTH/2081). Confirmation of Purity and Integrity of Antibody.

SDS-PAGE Analysis of Purified Ferritin, Heavy Chain Mouse Monoclonal Antibody (FTH/2081). Confirmation of Purity and Integrity of Antibody.
Mammalian ferritins consist of 24 subunits made up of 2 types of poly-peptide chains, ferritin heavy chain and ferritin light chain, which each have unique functions. Ferritin heavy chains catalyze the first step in iron storage, the oxidationof FeI(II), whereas ferritin light chains promote the nucleation of ferrihydrite, enabling storage of Fe(III). The most prominent role of mammalian ferritins is to provide iron-buffering capacity to cells. In addition to iron buffering, heavy chain ferritin is also involved in the regulation of thymidine biosynthesis via increased expression of cytoplasmic serine hydroxymethyltransferase, which is a limiting factor in thymidylate synthesis in MCF-7 cells. Light chain ferritin is involved in cataracts by at least two mechanisms: hereditary hyperferritinemia cataract syndrome, in which light chain ferritin is overexpressed; and oxidative stress, an important factor in the development of aging-related cataracts.
There are no reviews yet.